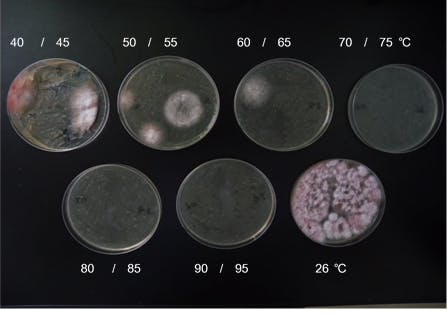

【はじめにご挨拶】
日本人が食しているバナナのほとんどがフィリピンから輸入されています。世界に拡大しているバナナの難病で、有効な農薬が無い【新パナマ病】菌に汚染された土壌を無農薬で浄化し、バナナ栽培地を再生するプロジェクトです。東大とフィリピン大学の植物病理の農学博士も参画しています。被害で困窮している零細農家を支援してください。
【このプロジェクトで実現したいこと】
バナナを枯らす熱帯性植物の土壌病原菌による【新パナマ病】の国際的被害拡大を克服、抑制するきっかけとするためにご協力を宜しくお願い致します。
世界の中でも東南アジアを中心に拡大している新パナマ病菌(原因菌は黴菌の一種、糸状菌のフサリウム.オキシポラムTR4)によって被害をもたらす汚染土壌を無農薬で適正加熱減菌浄化して、再発生防止対策技術を広めるプロジェクトです。
この病害で疲弊している零細な栽培農家の圃場を土壌にも動物にも薬害の無い、適温減菌と抗菌防護膜で、安全で効果の長く続く技術、方法を伝え、広めて零細農家の生活再生支援を行なう。
実行期間は、およそ18か月を見込んでいます。対象候補地は、マニラ南方60kmあるバナナ栽培地アマデオ地区です。
支援金の使途は次の通りです。(200万円をご支援いただいた場合)
1 渡航、滞在費、現地移動費 60万円
2 資材費(浄化装置製作費、発電関係費) 40万円
3 フィリピン大学専門家の検証実験協力礼金 40万円
4 現地作業者礼金 40万円
5 リターン品、作業進行報告関連費 20万円
新パナマ病源菌にたいしての本対策の有効性は国立群馬工業高等専門学校の農学博士、宮越俊一教授によって確認済です。この考案は既に特許申請済です。(特開2018-119254)
東京大学農学部門、植物病理学の志柿俊朗農学博士もこの計画に共同参画しています。先生は熱帯地域の植物の病気を長く研究されています。更にフィリピン最高水準の国立フィリピン大学ロスバニョス校(農学部所在地)の博士(Dr. Doloresほか)も協力していただけます。 ドロレス博士からの英文と訳文参照してください。



【この計画をおこなう理由】
被害地は赤道付近の熱帯地域各地です。この病気に有効な薬剤は未だに開発されていません。汚染被害が拡大の一方です。その結果、零細な栽培農家の収入減少による生活困窮を招きます。その解決のために、まずは、考案の有効性をフィリピンの栽培地で実証していきます。
【新パナマ病とは?】
新パナマ病問題の現状を簡略にご説明します。
私たちが食べているバナナは種無しです。遺伝学的には同一種で株分けの移植で増やします。世界に流通している種類はキャベンデッシュ種がほとんどです。黴菌の一種、フサリウム菌オキシスポラムTR4という、糸状菌の特定菌種によって、土壌が汚染されて急速に拡大しています。この菌は土壌内に生息し地下茎から侵入して茎の地表付近で増殖し維束管(バナナの茎)を塞ぎ、養分の供給をさまたげて成長を止めてしまいます。結果、そのバナナは枯死します。農薬に対してこの黴菌は30年近くも土壌中に生息して、再活性する性質を持っています。まるでゾンビです。美味しかった台湾バナナ産地がこの菌で壊滅しました。
国連食糧農業機構でも大きな問題としています。
(参考:http://www.fao.org/world-banana-forum/projects/fusarium-tr4/disease/en/)
【これまでの活動】
この被害状態を無農薬で抑制する技術を2016年に考案しました。
2017年、この考案の効果を国立群馬工業高等専門学校の農学博士宮越俊一教授と共に近似種類菌にて研究実証しました。効果を確認できたので2017年に特許申請しました。現地の情報を得るために、2018年2月にマニラにあるJICA事務所での現地情報収集とバナナ栽培地にて現地協力者と被害調査をしました。
日本国際協力機構(JICA)に支援提案を2018年10月30日にしました。
JICAの見解は採択には、現地での実証実績が必要であるとのことでした。そのために皆様のご支援で実績を作れるようにご理解をお願いします。
【バナナの需要】
アジア各地の人はお米を、欧米人は小麦を主栄養源にしています。バナナを主栄養源としている人々はアフリカ、インドを含めて数億人います。先進国の人々には栄養に富んだデザートとしてのバナナです。バナナを主要輸出農産物としているフィリピンのミンダナオ島では既に一万ヘクタールほどが被害を受けているとの情報もあります。
多くは零細栽培者が被害を受けています。大規模栽培者は消極的予防対策管理として消極的対策が整いつつあります。資力の乏しい零細栽培者の汚染した土壌は放置されてしまいます。
日本に輸入されているバナナはフィリピンからが大部分です。フィリピンに対象を絞りまして皆様と共に被害を減少させる活動をしたいです。親日国のフィリピンには協力してくれる友人が何人かおります。2018年の1月から2月に現地調査をしてきました。マニラのJICA(日本国際協力機構)からも情報提供を得ました。
写真1. 日本、フィリピン両国国旗とJICAマニラ事務所を訪問した考案者兼計画者 中川栄一
写真 2. 共同推進者の 志柿俊朗農学博士と中川栄一 東大安田講堂前
写真 3. 4. 協力をしてくれる現地の友人たち
写真 5. 6. バナナ畑の病気被害写真 新パナマ病とシガトカ病による耕作放棄地例。
【現状の対応策】
この病気に有効な効率の良い農薬はありません。世界の研究者が食用の種無し種と食用に適さないが種有種の交配を試みていますが、新品種は生まれていません。遺伝子操作による新種の開発も進んでいません。クローン株の研究は行われています。
2018年1月から2月に、現地の情報を得るために、考案者中川はフィリピンのマニラにあるJICA事務所に伺いました。
◉そこで得た情報 その1
数百ヘクタール単位もの栽培地を持つ、日本資本や米国資本の大規模栽培者は新パナマ病にたいしては未汚染地区に菌の侵入を防ぐために栽培地入場者の足元と使用機材の消毒による区域入場規制および一部では汚染土壌の焼却消毒などの対応をしています。
◉情報 その2
フィリピン日本人商工会議所 会報2017年11月、12合併号によりますと、バナナ産業で大問題の病気は新パナマ病とシガトカ病であり、その対策が難しい課題であると記されています。過去の薬害被害については【参考文献 中村洋子著 フィリピンバナナのその後 七つ森書館】に詳細が記されています。
現地の零細栽培者は有効な対策を出来ていません。汚染菌が土壌中に拡大してしまえば、その畑はバナナ耕作放棄地です。
土壌の焼却消毒は適切に行なわれれば菌の浄化目的は短期的には有効策です。しかし、汚染土壌の焼き畑的消毒は数百度の高温で有用菌まで殺菌し、かえって土壌地力を削いでしまいます。さらに焼き消毒方法では焼いた土壌への菌の再侵入を防げません。地元の研究所では病気に強い苗のクローンを開発して試験を行っているとの情報もあります。
我々の方式は汚染土壌の各種の有害菌を無農薬で浄化しさらに土壌内の微生物バランスを良好にして土壌が再汚染しにくい対策を行うことが特徴です。バナナ以外の農作物に被害をもたらす有害菌にも対応可能な手段方法です。

写真 1. 現地調査のために訪問したマニラのJICA事務所にて考案者中川

写真 2 共同推進者の志柿俊朗農学博士と中川栄一 東大安田講堂前にて


写真 3. 4. 現地の協力者と考案者

写真 5 新パナマ病に罹患した株
【資金の使い道】
ご支援頂いた資金は汚染栽培地で、本技術の有効性を実証するために、土壌浄化した栽培地で育成、収穫をするために使わせていただきます。正常に収穫できた結果を得られたら、この考案技術の有効性を現地の零細農家に伝えて、さらに、フィリピン政府などに働き掛けます。東大の植物病理の農学博士志柿俊朗先生とフィリピン大学ロスバニョス校のドロレス博士も協力していただけます。
【ワーキングプロセスの概要を説明します】
本プロジェクトの考案を説明します。基本は汚染株一つ毎の確実な対症対策です。一網打尽ではありません。
汚染発症のバナナ茎葉は伐根、伐採後焼却します。
↓被害バナナの株根の範囲一㎡位の汚染土壌を掘り出して考案した加熱装置槽に移します。
↓汚染された土壌を浄化するために加熱殺菌を熱効率の優れた省エネ発熱体で行います。電源は可搬発電機より得ます。
↓掘り出した土壌窪地の範囲に菌の再侵入を防止する抗菌防護膜を設けます。この膜には抗菌力のある金属微粒子を付着してあります。金属微粒子は世界的に厳しい規制の米国で土壌汚染や生物への安全性を確認されています。登録番号(EPA Reg. No84610E)加熱浄化後の土壌を埋め戻して上面を抗菌防護膜で覆います。
↓そこに新しい株分け苗を植えて通常の生育管理をします。収穫まで10ケ月程度かかります。
以上のプロセスで行います。
つまり、株の根を囲って菌を防いで一種の水耕栽培のようになります。
- 図2. 熱処理に伴う土壌中の各種菌群の菌数の変化
フザリウム菌は浄化し、土壌に良いバクテリア細菌は増殖

土壌加熱処理後の対象菌の減少状態 下段 右 加熱してない繁殖状態

抗菌保護膜の菌遮断効果 中央は菌繁殖し放題のシャーレ
左右は保護膜で菌が遮断減菌されて、拡大繁殖出来ないシャーレ
国立群馬工業高等専門学校による共同研究報告書 より抜粋
研究担当教授 農学博士 宮越俊一先生提供
【本考案の長所】
宮越農学博士のレポートにあるように、この考案は無農薬であり、加熱温度帯では対象有害菌は浄化されますが、栽培土壌にとって有用な枯草菌などの有用菌が増殖して土壌が豊かになります。抗菌保護膜は菌の再侵入汚染を抑制します。
一株必殺の技です。
【本考案の短所】
栽培畑に点在する汚染株毎に対処します。一網打尽にはまいりませんので効率性を上げる工夫が必要です。
国立群馬工業高等専門学校の農学博士、宮越教授による共同研究報告にあるように現地で汚染土壌を同じ温度環境にすれば無農薬で、作業者にも安全で質の良い土壌に再生出来ます。評価者の宮越博士の判定によりますと有効な方法です。
残念ながら、この原因菌フサリウム.オキシスポラムTR4は有害菌のために日本国内では入手できないために国内農地での実験が許可されません。同種近似菌の研究結果です。したがって、現地で実証することが必要になります。
この対策方法の最終の有効性評価は
汚染土壌を浄化して苗バナナから育て上げた果実が正常に実って評価されます。
【リターンについて】

【 トートバック 写真 】
1口5,000円ご支援いただいた皆様にはSAVE BANANA独自ロゴ入りデニム製トートバッグ(サイズ36 cm×37 cm×11cm)とご支援の礼状をまず、送らせていただきます。さらに、作業実施報告写真を開始前段階、浄化段階、苗植え付け段階、生育段階、結実段階の写真を送らせて頂きます。
1口10,000円ご支援いただいた皆様にはトートバッグ、礼状、上記写真報告とバナナをドライバナナにして送らせていただきます。
1口20,000円ご支援いただいた皆様には上記のほかに、現地の農家または行政機関の礼状を添えさせていただきます。
成果が出るまでには計画着手から新苗成長後の収穫まで18か月近くの時間がかかります。
【実施スケジュール】
9月ころから、対象候補地である、マニラの南60 kmほどにあるアマデオ地区の栽培地にて汚染株の選定作業開始。逐次、浄化工程、新苗植栽、生育管理を行います。
本考案による対策の実績を重ねて、日本国政府の途上国支援組織である日本国際協力機構(JICA)のODA支援対象になれる道筋もあります。
【最後に】
本計画は現地の多くの零細栽培者の生活再建支援になります。さらにこの対策方法は広くは世界のバナナ栽培者の新パナマ病害対策支援になります。広い視点でご理解を頂き、多くの皆様のご支援をお待ちいたします。





コメント
もっと見る